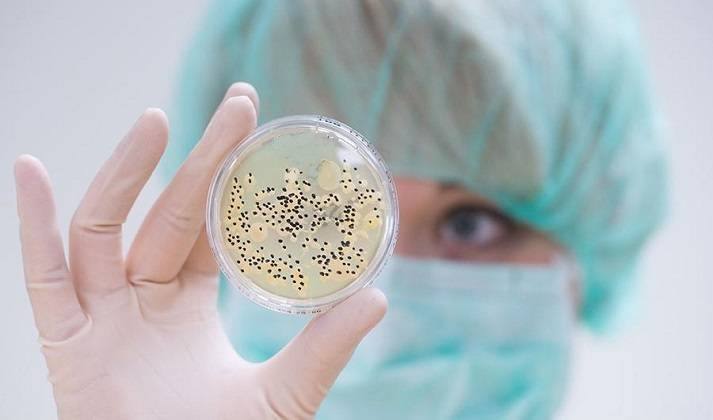

Что такое мукормикоз, и как «черная плесень» проявляется у человека

Как проявляется мукормикоз или «черная плесень» у человека, рассказали врачи. В Сети появилось много фотоснимков этой патологии из-за повышения случаев заражения людей коварным грибком. В описании мукормикоза есть причины, приводящие к летальному исходу.
Что собой представляет мукормикоз
В медицинских кругах под мукормикозом, или «черной плесенью», подразумевают одно из заболеваний, вызванное грибками. В основном они находятся в окружающей среде – в земле, навозе, на пропадающих фруктах и овощах.

Грибки питаются разлагающейся органикой. Найти их можно, как в грунте и воздухе, так и в носовой полости людей. Попадая в организм здорового человека, теряют свои агрессивные свойства. Найти их можно, как в грунте и воздухе, так и в носовой полости человека.
Но при определённых обстоятельствах, грибки семейства Mucorales, приводят к развитию тяжёлого и коварного заболевания. Оно зачастую приводит к инвалидности и летальному исходу.
Как сообщается на портале 1rre.ru, мукормикоз в основном диагностируется у людей с ослабленными иммунитетом. Врачи отмечают, что чаще всего «черная плесень» поражает человека, если он подвержен:
- сахарному диабету;
- ВИЧ или СПИД;
- онкологическим заболеваниям.
Встречаются и случаи поражения мукормикозом и тех, кто болеет, или недавно перенёс коронавирусную инфекцию.
Как проявляется мукормикоз у людей
Одними из первых симптомов, которые наблюдаются у человека, чей организм поражён грибком семейства Mucorales, являются заложенность носа или частые кровотечения из него.
Споры «черной плесени» люди могут вдыхать в привычной обстановке. Они оседают на слизистой носа. Если иммунитет человека в порядке, то внешний патоген быстро нейтрализуется, и не может спровоцировать развитие опасного заболевания – мукормикоза.

По мере распространения грибков, начинают проявляться и другие симптомы. Чаще всего у человека с «черной плесенью»:
- опухают и болят глаза;
- опускаются веки;
- ухудшается зрение;
- наблюдается потеря зрения на один или оба глаза;
- вокруг носа может наблюдаться почернение кожи.
Патоген поражает не только слизистую носа, но и затрагивает близлежащие ткани – нёбо, носовую перегородку, дыхательные пути, легкие. Если заболевание протекает стремительно, или пациент долго не обращается за медицинской помощью, то грибки «добираются» до головного мозга. Тогда возрастает риск наступления летального исхода.
Как диагностируется и лечится «черная плесень»
О том, что человек страдает от мукормикоза, свидетельствует не только первичная симптоматика заболевания. В медицинском учреждении проводится ряд лабораторных и диагностических манипуляций.
Зачастую, чтобы спасти жизнь пациентов, проводятся сложные хирургические вмешательства. С их помощью удаляется не только ткани, подвергшиеся некрозу – разрушению. Бывают случаи, когда врачам приходится лишать человека одного или двух глаз, нижней челюсти, носовых перегородок.
Используется и дорогостоящие препараты.
Где зафиксированы случаи мукормикоза
Наибольшее количество людей, у которых диагностирована «черная плесень», выявлено в Индии. Коварное и опасное заболевание выявляется у тех, кто болеет или перенес коронавирусную инфекцию.

Врачи связывают это с несколькими факторами. При лечении COVID-19, зачастую используются препараты, содержащие стероиды. С одной стороны, они помогают снимать воспаление легких. С другой стороны – снижают иммунную защиту организма и повышают сахар в крови.
Если учитывать, что в группе риска «черной плесени» находятся люди с ослабленным иммунитетом, а также подверженные сахарному диабету, то стероидные препараты могут выступать своеобразными «провокаторами» развития мукормикоза.
ЧИТАЙТЕ ТАКЖЕ: В Индии зафиксирован случай грибкового заболевания, получившего название «зелёная плесень»
К слову, в Индии зафиксированы 4 разновидности грибковых заболеваний:
- «черная плесень»;
- «белая плесень»;
- «желтая плесень»
- «зеленая плесень».
Все они довольно коварны, и могут привести к летальному исходу. Заболевания с грибковым патогеном фиксируются в Индии среди тех, кто был инфицирован коронавирусом.
<!--
